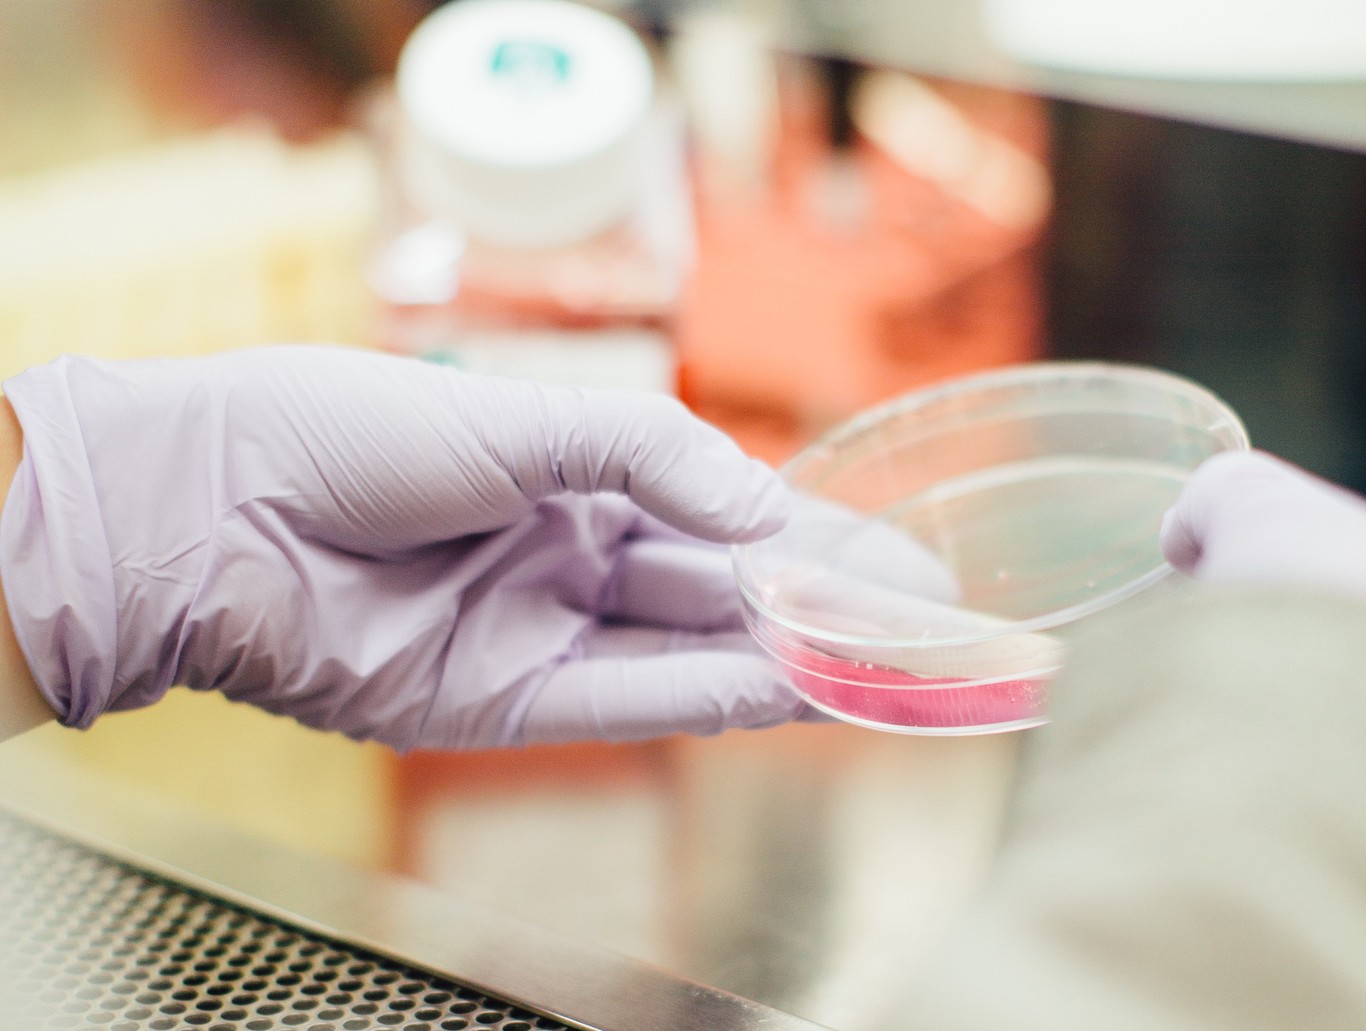
Estas son las primeras células inmunitarias reprogramadas y suponen todo un hito de la medicina moderna

Warner afirma que algoritmos de IA guiarán a sus directivos sobre qué películas hacer, con qué actores y cuándo estrenar

Según ha adelantado esta mañana Hollywood Reporter, Warner Bros ha firmado un acuerdo de colaboración con Cinelytic para usar su herramienta de gestión de proyectos basada en inteligencia artificial. La idea es, apuntan en el medio, usar «los datos integrales del sistema y el análisis predictivo para guiar la toma de decisiones en la etapa de aprobación de proyectos», es decir, usar la IA para valorar el impacto de cierto actor o actriz en cada territorio y obtener una predicción de la taquilla de la producción.
Que se sepa, no es que la IA vaya a tener la última palabra en las decisiones ejecutivas, sino que servirá como una especie de consejera. En palabras de su fundador, Tobias Queisser, «el sistema puede calcular en segundos lo que solía llevar días evaluar por un humano cuando se trata de la evaluación general de una película o el valor de una estrella». Este, a su vez, afirma «la inteligencia artificial suena aterradora, pero en este momento, una IA no puede tomar decisiones creativas«.
Lo que promete Cinelytic
Cinelytic afirma en su web que su objetivo es «empoderar a la industria mundial del entretenimiento a través de herramientas y tecnología de vanguardia» y «combinar las mejores prácticas de los sectores de entretenimiento, finanzas, ciencia y tecnología para brindar a los tomadores de decisiones en la industria del entretenimiento acceso a los conocimientos que necesitan para optimizar su desarrollo de contenido, financiamiento, producción y decisiones de distribución».
La empresa fue fundada por Tobias Queisser y Dev Sen hace cuatro años y su plataforma estuvo en fase beta durante tres de ellos. Entre sus clientes están Ingenius, Sony Pictures, STX y ahora Warner Bros y, según exponen en su página web, su inteligencia artificial tiene más de un 85% de precisión en el pronóstico de taquilla. Dentro de la plataforma se puede acceder a más de 95.000 películas con su respecto rendimiento y metadatos y a los perfiles de más de 550.000 estrellas de cine.

Y es que una de las grandes promesas de Cinelytic es, precisamente, el análisis predictivo. Desde su plataforma se puede acceder a un enorme catálogo de películas, ver su rendimiento económico por países, el coste de sus actores (ahora hablaremos de esto) y, según la imagen de demo, hasta obtener una predicción de cuánto dinero se generará en taquilla, por ventas de DVD o VOD, televisión gratuita y de pago, etc.
Asimismo, la base de datos de actores y actrices promete obtener «información crítica sobre cómo las estrellas clave aumentarán las posibilidades de éxito de un proyecto y en qué medida». Para ello, cuentan con un sistema de puntaje económico (Cinelityc’s TalentScore) que «clasifica a las estrellas por su impacto económico en la industria del cine, incluso por tipo de medio, género y territorio».

En la imagen superior puede verse el ejemplo de Gal Gadot. A falta de saber si es un ejemplo real o no, de acuerdo a la IA de Cinelytic, la actriz israelí tiene mejor desempeño en Estados Unidos, Australia o Mexico, mientras que en países como Países Bajos, Turquía o España el rendimiento es más bajo. Para la revista Screen International, Cinelytic hizo un listado con las actrices que mejor rendimiento ofrecen por países, afirmando que, por ejemplo, Emma Watson triunfa en Reino Unido y Francia, mientras que Scarlet Johansson lo hace en Estados Unidos.
Explican que esa medida está basada en la «rentabilidad de un talento de acuerdo a su taquilla, tomando en consideración la filmografía de cada persona y el peso de su personaje o rol» y que «no se tienen en cuenta películas antiguas ni apariciones animadas o cameos». Usar esta herramienta pasa por pagar una suscripción de «miles de dólares», algo que tiene sentido puesto que se puede personalizar para, por ejemplo, incorporar los datos del estudio.

Por último, Cinelytic cuenta con un «conjunto de herramientas de análisis de películas» para ejecutar «múltiples escenarios de composición de películas, escenarios de lanzamiento y análisis por territorio y por distribuidor, todo en cuestión de minutos», es decir, que afirma ayudar a la hora de elegir, por ejemplo, cómo lanzar la película, cuándo y en qué países hacerlo.
La IA como apoyo para tomar decisiones

Más allá de esto, lo cierto es que no es la primera vez que un algoritmo ayuda a una empresa a decidir por qué contenido apostar. Uno de los ejemplos más conocidos es ‘House of Cards‘, que está basada en una serie de 1990 de la BBC y que ha sido un éxito gracias, en parte, al Big Data.
Es algo que podía intuirse, puesto que un algoritmo analizó los gustos y preferencias de los suscriptores para detectar que estos veían películas de David Fincher y que Kevin Spacey gustaba como protagonista. Ambos trabajaron en ‘Seven‘, por cierto. El algoritmo detectó también que el género predilecto era el drama político y que los usuarios querrían ver la serie de golpe, así que en 2013 se lanzó la primera temporada de ‘House of Cards’.
Algo parecido sucede con ‘Strangers Things’. La portada que aparece cuando pones el cursor sobre la serie no es la misma para todo el mundo, sino que se muestra la que es más probable que te llame la atención, según qué personajes o géneros te gusten. Puede parecer algo simple, pero Netflix afirma que su algoritmo de personalización vale mil millones de dólares al año.
FUENTE